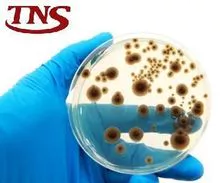
imagem dos produtos

更多关于
TNS Nanotecnologia
未通知
未通知
未通知
未通知
Year
成立年份
业务类型
- Industry / Manufacturer
关键词
- 抗菌剂
- 纳米技术
- 真菌
- 细菌
- 创新
- 封装 Ver Mais
联系方式和位置
-
TNS ********
-
+55 48********
-
Florianópolis / SC | 巴西